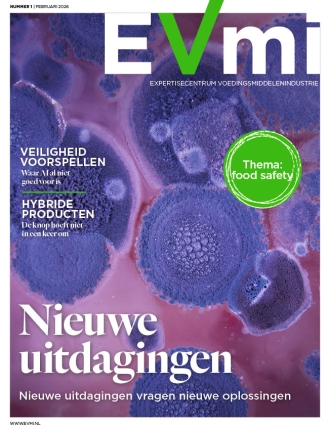
EVMI 1 2026

EVMI
Jaarabonnement (8nrs) EVMI
Prijs
€ 19,99
Kioskprijs
€ 62,50
Platform voor de professional in de voedingsmiddelenindustrie
EVMI is een vakblad gericht op de voedingsmiddelenindustrie. Via het magazine, de website, wekelijkse digitale nieuwsbrieven en jaarlijkse congressen houden we professionals uit de industrie op de hoogte van actuele ontwikkelingen in de foodsector. Ook biedt EVMI inzicht en advies door middel van achtergrondartikelen en interviews met experts.
Iedere uitgave van het magazine wordt een actueel thema uitgediept. Daarnaast bestaat het magazine uit drie helder te onderscheiden katernen – Food Innovatie, Management en Proces & Techniek – en interessante vaste rubrieken. Op de website worden dagelijks nieuws en achtergronden geplaatst.











